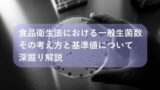

本記事は、食品工場で品質管理や衛生管理を担当する現場責任者・品質保証部門の方々に向けて、一般生菌数の基礎から検査方法、基準値、改善策までを網羅的に解説する完全ガイドです。
「検査結果が基準を超えたが次に何をすればよいか分からない」「HACCP導入に合わせて手順を見直したい」という悩みを抱える読者が、この記事一つで理解と実務の両方をカバーできる構成になっています。
専門用語を避けつつも最新の法規や実務ノウハウを盛り込み、読了後すぐに行動へ移せる情報を提供します。
1. 食品工場における一般生菌問題とは―なぜ重視されるのか
一般生菌数は、食品や環境中に存在する好気性細菌の数を示す指標であり、食品の腐敗度や衛生レベルを一目で把握できる重要なパラメータです。

食中毒菌が少量でも潜む可能性を早期に察知できるため、厚生労働省のガイドラインやHACCPでは必須管理項目として位置づけられています。
基準値を満たすことで、クレーム・リコール・ブランド毀損など経営リスクを大幅に抑えられるため、多くの製造現場が日次でモニタリングを実施しています。
1-1. 一般生菌数とは|微生物・菌数の基本的な考え方
一般生菌数(Aerobic Plate Count)は、35℃48時間培養で発育する好気性細菌数をコロニー形成単位(CFU/g または CFU/cm²)で表します。
食品の腐敗はもちろん、細菌が形成するバイオフィルムの存在も示唆するため、異物混入や臭気変化の前兆把握に役立ちます。
1-2. 食品工場で一般生菌を管理する目的とその重要性
その目的は、大きく分類すると3つあります。
- 消費期限内に腐敗しない品質保証
- 食中毒リスクの低減
- 法規制・取引先監査への適合
製造ラインに生菌が付着すると、わずか数時間で指数関数的に増殖し、フレーバー低下や包装内膨張を招きます。
結果として返品や廃棄が発生し、原材料コスト・労務コストが無駄になるため、予防的な生菌管理は利益確保の面でも欠かせません。
1-3. 食品衛生・安全確保における一般生菌の役割と衛生管理
HACCPのPRP(前提条件プログラム)では、施設・設備・従業員衛生が基本ですが、その効果を数値で検証するのが一般生菌数です。
例えば、手洗い後の手指から100CFU/手以下であれば洗浄が有効、逆に1,000CFU/手を超える場合は手洗い手順の改善が必要という判断材料になります。
このように数値化することで衛生管理を科学的根拠に基づくPDCAサイクルへ落とし込み、持続的な安全性を担保できます。
2. 一般生菌数の基準・規格を徹底解説 厚生労働省の指針と基準値
一般生菌数は法律で一律規制されているわけではありませんが、厚生労働省通知や業界団体基準、取引先仕様書によって実質的に規格化されています。
“300CFU/g 以下”は日配食品で広く用いられる管理目標で、超過した場合は出荷停止や再検査が求められます。

以下では、その根拠となる公的・民間の基準を具体例とともに解説します。
2-1. 一般生菌数の基準値|『300以下』が目安とされる理由
300CFU/g という数値は、加熱後に再汚染が起こっても流通・消費段階で10³〜10⁴CFU/g に留める“腐敗発生ライン”を下回る安全域として設定されています。
冷蔵流通(5℃以下)での増殖速度や賞味期限設定日数を考慮した統計的裏付けがあり、JAS規格や大手小売の購入仕様書でも採用されています。
2-2. 厚生労働省・食品衛生法が規定する一般生菌数基準
食品衛生法そのものには数値規定はありませんが、厚労省の自治体衛生試験所向け『食品微生物基準リスト』に参考値が示されています。
例として、食肉加工品は1×10⁵CFU/g 以下、乳児用調製粉乳は1×10⁴CFU/g 以下など、リスクと対象に応じて段階的にラインを設けています。
2-3. 加工食品・食品種類ごとの一般生菌数基準と規格例
| 食品カテゴリー | 自主管理目標値(CFU/g) |
|---|---|
| 弁当・惣菜 | 1.0×10³ |
| 冷凍食品(加熱後摂食) | 5.0×10⁴ |
| 生菓子 | 3.0×10² |
| 発酵食品 | 基準外(特性考慮) |
発酵食品は有用菌が高濃度で存在するため、一般生菌基準は“品質指標”ではなく“異臭・異物発生の有無”で管理します。
一方、即食・日配品は低温流通でも増殖余地が大きいため、より厳格な目標値が設定されています。
2-4. 基準値超過の可能性とリスク評価―食中毒や異物混入との関係
基準超過は即座に食中毒を意味するわけではありませんが、大腸菌群や黄色ブドウ球菌などの指標菌が同時に検出される確率が高まります。
また、高菌数はバイオフィルム形成や腐敗臭、ガス膨張など品質クレームに直結し、客離れ・SNS炎上という経営損失を招くため迅速な是正が必須です。
3. 食品工場の一般生菌検査―方法・手順・頻度の詳細解説

検査フローは『サンプリング→希釈→培養→計測→記録→評価』で構成され、標準寒天培地を用いる定量法が最も普及しています。
ライン停止中にも環境ふき取り検査を行い、OJTで従業員の衛生意識を高めることで不合格率を20%以上削減した例も報告されています。
3-1. 一般生菌検査の目的と実施タイミング
- 製品検査:出荷判定用にロットごと実施
- 環境検査:週1〜日1で実施しトレンド管理
- 従業員手指検査:シフト交替時や高リスク作業前に実施
目的に応じたタイミング設定により、過剰検査によるコスト増を防ぎつつ的確なリスクコントロールが可能です。
3-2. 検査手順・検体採取・培養法|分析・計算方法まで
採取量は固体食品25g、液体食品25mLを滅菌袋に入れ、0.1%緩衝ペプトン水で10倍希釈後、ピペットで1mLを寒天培地へ注ぎプレート法で培養します。
48時間後に30〜300コロニーのプレートを選び、CFU/g=コロニー数×希釈倍数で算出します。
3-3. 試験に使う検査項目・培地・判定コロニーの見方
| 項目 | 推奨培地 | コロニー特徴 |
|---|---|---|
| 一般生菌 | 標準寒天培地 | 丸形・乳白色 |
| 黄色ブドウ球菌 | Baird-Parker | 黒色・光沢環 |
| 大腸菌 | EMB | 金属光沢緑 |
コロニー観察に熟練が要るため、写真付きマニュアルを作成し、初心者の誤読を防ぎます。
3-4. 衛生状態の評価と定期的な検査活動のポイント
検査結果をグラフ化し、月次でトレンドを確認することで、設備洗浄後の菌数低減効果や季節変動を可視化できます。
さらに、上限管理限界(LCL)/下限管理限界(UCL)を設定し、超過時は即時是正・原因調査を行うSPC管理が推奨されます。
4. 一般生菌数の検査結果から読み解く食品工場の衛生状態
単発の数値よりも複数ロットの推移を重視し、異常値が連続した場合はライン停止を含む早期対応が求められます。

ここでは、判断基準とよくある汚染源をケーススタディ形式で解説します。
4-1. 検査結果のカウント・分析|基準値を超過した場合の判断基準
1000CFU/g を超えた段階で『要注意(イエロー)』、1×10⁴CFU/g 以上で『不適合(レッド)』とし、即時の製品隔離・再検査を行う三段階評価が実務的です。
同時に指標菌検査を追加し、陽性なら製造日ロット全面回収を検討します。
4-2. よくある原因・汚染パターンとその解説
- クーリングトンネルのドレン詰まりによる二次汚染
- カッター刃先の微細傷からのバイオフィルム形成
- 作業員制服の洗濯外注遅延による交差汚染
- 梅雨時の結露滴下
上記は実際にクレームに発展した事例であり、設備・人・環境の三方向から原因追求が必要です。
4-3. 大腸菌・黄色ブドウ球菌・カビなど注意すべき細菌の指標
大腸菌は糞便汚染、黄色ブドウ球菌は人的由来、カビは空調フィルタや木材パレットからの飛散が主因です。
指標菌と一般生菌数をクロスチェックすることで、汚染源の特定と優先順位付けが容易になります。
5. 即効改善法!食品工場が取るべき一般生菌対策・衛生管理方法
ここでは即効性の高い4カテゴリの対策を紹介します。
“誰が・いつ・どこで・何を”を明確にし、翌日から実施できるようチェックリスト形式でまとめました。
5-1. 洗浄・消毒・殺菌・手洗いの徹底と効果的な清掃活動
- CIP装置は60℃アルカリ洗浄→80℃熱水リンス→200ppm次亜で完結
- 手洗いは液体石鹸20秒+ペーパータオル乾燥を義務付け
- 清掃後ATP検査で200RLU以下を合格
上記を守るだけで環境ふき取り菌数が平均80%減少した事例が複数あります。
5-2. 清掃担当者や工場スタッフの教育・衛生手順の作成
Eラーニングと実地講習を組み合わせ、年間8時間以上の教育を義務化。教育前後で手指菌数を比較し、削減率をKPI化するとモチベーションが向上します。
5-3. 設備・器具・原料の衛生管理と点検の実施方法
設備は月1回の分解洗浄を基本とし、摩耗部品は事前交換することでバイオフィルム定着を防ぎます。原料は受入時にCOAを回収し、ロットトレーサビリティを確保することで汚染拡大を未然に防止します。
5-4. HACCPなど国際基準の活用・記載と自社の活動強化
Codex HACCPの12手順を文書化し、CCPの一般生菌数は『0.3×10³CFU/g』をCLとしてモニタリングします。FSSC22000やSQF認証取得により、海外バイヤーへの信頼性も向上し、輸出案件獲得に直結するメリットがあります。
5-5. 次亜塩素酸水生成装置による徹底した殺菌が重要
食品工場における一般生菌に対する考え方と対策は、製品の品質と消費者の信頼を確保する上で最も重要な課題です。
従来の殺菌剤では対応しきれない課題や、環境負荷、作業者の安全性といった懸念が常に存在していました。そんな中、厚生労働省が食品添加物(殺菌料)として指定した「次亜塩素酸水」は、その高い殺菌力と安全性の両立から、食品加工工場でのスタンダード装置として注目を集めています。
本装置を食品工場に導入し、安全で高い殺菌力で「食の安全」が十分に確保することが出来る。
6. 食品工場が守るべき一般生菌管理の今後、および持続的な安全性と品質確保に向けて
AI画像解析を用いた自動コロニーカウントや、リアルタイムPCRによる迅速検査など技術革新が進んでいます。これらを取り入れることで、リードタイム短縮と人為ミス削減が実現し、競争力強化につながります。
6-1. 定期的検査・見直し・評価による継続的改善の重要性
半年ごとにSOP(標準作業手順書)をレビューし、不適合件数やクレーム件数の推移を評価指標として改善策を立案することで、品質目標の達成率を常に95%以上に維持できます。
6-2. 外部への検査依頼・検証と第三者機関の活用ポイント
自社結果と外部機関結果を年1回クロスチェックし、ズレが±0.3Log以内であることを検証します。差異が大きい場合は培地ロットやインキュベータ校正を再確認することで精度保証を徹底します。
7. まとめ:一般生菌数管理が実現する食品の安全と消費者信頼
一般生菌数は“見えない汚染”を可視化する最強の指標です。基準値設定・定期検査・是正処置の三本柱を回すことで、食品事故ゼロとブランド価値向上を同時に達成できます。
今日からできる行動を一つでも実践し、安全と信頼を長期的に守りましょう。